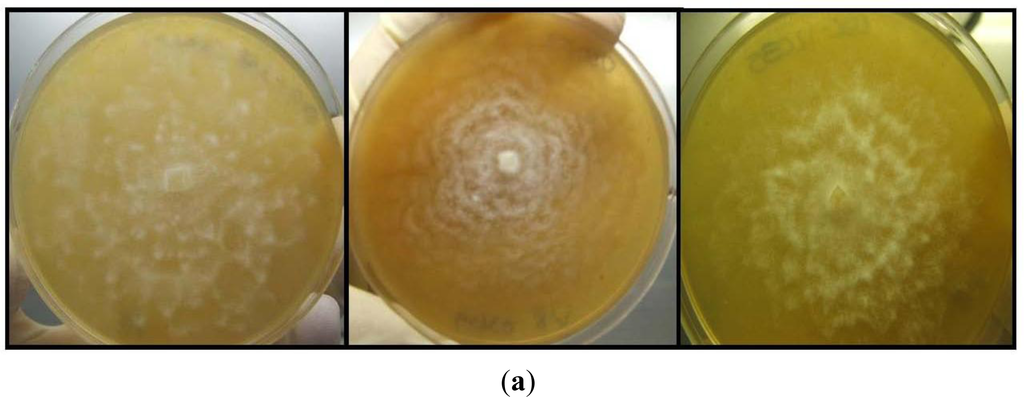

Abstract
Biting midges are globally distributed pests causing significant economic losses and transmitting arbovirus diseases to both animals and humans. Current biological and chemical control strategies for biting midge target destruction of adult forms, but strategies directed at immature stages of the insect have yet to be explored in Australia. In the present study, coastal waters of Hervey Bay region in Queensland, Australia were screened to detect the habitats of biting midge at immature stages. These results were then correlated to local environmental conditions and naturally occurring entomopathogenic fungal flora, in particular the Oomycete fungi, to determine their reducing effect on insect immature stages in the search for biological control agents in the region. The dominant species of biting midge found within this study was Culicoides subimmaculatus occuring between mean high water neaps and mean high water spring tide levels. Within this intertidal zone, the presence of C. subimmaculatus larvae was found to be influenced by both sediment size and distance from shore. Halophytophthora isolates colonized both dead and alive pupae. However, the association was found to be surface colonization rather than invasion causing the death of the host. Lack of aggressive oomycete fungal antagonists towards midge larvae might correlate with increased incidences of biting midge infestations in the region.
1. Introduction
Biting midges are common pests, found in many different countries and regions such as the USA, the Caribbean, Africa, Mexico, Canada, Scotland and Australia [–]. Australia has at least 70 species from the genus Culicoides [], including C. ornatus, found extensively within Northern Territory []; C. molestus [,] and C. subimmaculatus affecting South East Queensland []. Culicoides species are globally responsible for transmitting viral diseases of livestock and wild ruminants, such as African Horse Sickness Virus, Bluetongue Virus (BTV), Epizootic Hemorrhagic Disease Virus, Palyam Viruses, Equine Encephalosis Virus, Bovine Ephemeral Fever Virus (BEFV), and Akabane Virus []. Culicoides species are also suspected vectors of vesicular stomatitis virus, causing significant economic losses in cattle, horses and swine [] and are reported to transmit diseases to native wildlife including BTV to wild ruminants [,], hemorrhagic disease in white-tailed deer [], and blood parasites within birds [].
Of the two common South East Queensland species, C. subimmaculatus, is associated with the surface-tunneling crab Mictyris livingstonei McNeill, and found between mean high water neap (MHWN) and mean high water springs (MHWS) [] in areas of sand or sand-mud with minimal wave action []. C. molestus is found breeding along canal beaches in fairly clean flocculated sand between mean tide levels (MTL) and MHWS [,].
Residents in midge prone areas have limited options to control invading species [], with persistent attacks by swarms significantly impacting on work and recreational activities []. Due to adult biting-midge dispersal from their original source, treatments targeting adult populations are usually ineffective []. Immature stages of Culicoides species are more susceptible to treatment [], however, the costal species are located within the sensitive inter-tidal zones along beaches, estuaries and waterways out of easy reach [].
Possible treatment options for the control of biting midge can include larviciding, adult insecticidal fogging, barrier treatments or habitat modification. Adult insecticidal fogging is the application of aerosol particles against flying insects []. However, this method is usually ineffective and short-term [] due to rapid re-infestation, limited accessibility to treat large areas, and the significant costs involved []. Low specificity, emerging resistance, pesticide side-effects, toxic derivatives and long term environmental pollution [] from pesticide use have highlighted the need for non-polluting and safe pest controls such as the use of biological control agents. Advantages of biological control agents over chemicals are numerous, including safety of non-target species [], increased activity of natural enemies and increased biodiversity [].
The majority of insect orders are susceptible to pathogenic fungi [] with populations commonly affected by extensive epizootic disease events []. Entomopathogenic fungi are important regulators within insect populations, synchronization with the host’s lifecycle is commonly seen [] and diverse ranges of strategies from obligate parasitism to opportunistic pathogens have been observed [].
Many of the Oomycetes including Pythium, Phytophthora, Saprolegina, Aphanomyces, and Lagenidium are parasites of plants or animals using zoospores to infect their hosts []. Dominant marine Oomycetes are species of Halophytophthora [], which are probable decomposers of fallen leaves []. Investigations indicate that species of Halophytophthora are widespread in mangrove communities in southern coastal Queensland []. The Oomycete Lagenidium giganteum is a facultative fungal pathogen of mosquito larvae [] and has been registered for use as a mosquito biological control agent with the United States Environmental Protection Authorities [,], and successfully controls mosquitoes from the genera Anopheles, Aedes, Culex, Culiseta and Psorophora [].
In Australia, past research has identified two fungal species entomopathogenic to biting midge larvae. Naturally occurring fungal species in Northern New South Wales, L. giganteum produced mortality rates of up to 33% against C. molestus larvae []. A study by Unkels et al. [] has also shown Culicinomyces clavosporous to be highly pathogenic to the larvae of C. nubeculous []. The study reported here is a further investigation into the presence of naturally occurring entomopathogenic oomycete fungi against biting midge larvae within Hervey Bay, Queensland, in order to assess their potential as biological control agents and a safe alternative to chemical control in the region.
2. Experimental Section
2.1. Sampling Sites
Sampling was conducted at four locations within Hervey Bay, including River Heads, Urangan, Eli Creek and Beelbi Creek (Table 1). Sampling locations were chosen due to the known presence of adult biting midge within the area and to ensure that samples were derived from both open beach, estuarine intertidal and creek environments. Table 2 lists Halophytophthora isolates found in Harvey Bay.
Table 1.
Summary of transects sampled within the four study locations of Hervey Bay.
Table 2.
Halophytophthora isolates from Hervey Bay.
At each transect site, environmental parameters included sediment characteristics, mangrove density and the distance at which larvae occurred within the tidal plain to identify any significant associations with biting midge larval habitats and these parameters within Hervey Bay []. Other environmental variables such as water salinity, temperature and pH were also measured to describe their effect on the larval and fungal habitats (Table 3).
Table 3.
Details of environmental variables found in sampled locations where Halophytophthora were isolated.
The association between larvae abundance and mangrove density was also tested in a single transect taken longitudinally along Eli Creek mouth, where changes in mangrove density could be measured in relation to biting midge larvae being present. The sorting of sediments fell into five categories from “very well sorted” to “poorly sorted” and their relationship to larval presence was analyzed (sediment sorting is the measure of the range of grain sizes and spread of these sizes around the mean particle size within each sediment sample []).
2.2. Larval Sampling and Extraction
Samples were collected by transecting the intertidal zones from above mean high water springs (MHWS) to beyond mean high water neap (MHWN) at low tide. Larvae were sampled by digging a channel 1 m long, 4 cm deep, and 4 cm wide with a hand shovel at measured points along each transect. Points sampled for larvae were dictated by the overall distance covered by each individual transect, and ranged from one to twenty meters apart. Samples were stored within large zip-lock plastic bags, and kept at room temperature in the shade, for up to 48 hours before processing.
Larvae were then extracted using two different separation methods. Sugar-flotation method was used for samples composed of sands or sand-silt substrates, whilst a salt flotation method [] was employed for samples with higher silt/clay proportions. When using sugar flotation, the sample was flooded and mixed with a 2:8 parts molasses water mix, and then allowed to settle for 30 minutes in 1 L plastic measuring cylinders. After settling, the top liquid layer was first sieved through a large generic sieve, then a fine (63 micron) sieve. The fine sieve was then rinsed out into a clear plastic holding container with tap water to extract the larvae. Salt flotation followed the same method as sugar flotation however, a ∼40% w/v Epsom Salt solution was used with all samples settled and sieved twice before discarding. Extracted larvae were refrigerated in sealed containers of tap water, with counting and identification completed within 24 hours after extraction.
2.3. Larval Identification
Methods for enumeration and identification of larvae were obtained from the Tweed Heads Shire Council. Holding containers of larvae were placed over a black ceramic tile and the larvae excited into swimming by using a strong light source and a plastic bulb pipette to disturb any sediment present. Excited larvae were then easily identifiable by their distinct swimming pattern, and white coloration against the black background.
After counting, larvae were stored within a refrigerator at 4 °C for up to 12 hours to initiate a state of immobilization resulting from the decreased temperature. Identification was then conducted on immobilized larvae by observing head struts and pigmentation patterns along the thoracic region of the insect body. Any larvae displaying discoloration were isolated for comparison with healthy larvae to determine if a fungal infection was present. These discolored larvae were later used to attempt isolation of fungal isolates.
2.4. Fungal Isolations and Identifications
Samples for fungal isolations were taken from transects within each of the sampled four locations within Hervey Bay (Table 1). Samples taken along each transect included water, composite samples of leaf matter and sediment. Leaf and sediment samples were collected and stored in zip-lock plastic bags whilst water samples were stored in sterile 100 mL screw top containers. All samples were kept on ice for transport and refrigerated at <4 °C while in storage.
For isolations, both direct and conventional serial dilution techniques were used. For direct isolations of fungi three individual leaves of varying decomposition were selected and surface sterilized subsequently []. After surface sterilization, each leaf was dissected into small squares using a sterile scalpel and aseptically placing onto 3P agar, selective for Phytophthora and other oomycete species []. A serial dilution, adapted from Sylvia et al. [], was performed on both the water and sediment samples. Before diluting, sediment samples were shaken for 20 minutes with a Griffin Shaker and water samples vortexed to create a homogenous sample, with aliquots from selected dilutions plated.
Fungal isolation was also carried out from larvae displaying symptoms of possible fungal infection. Larvae were surface sterilized by soaking in a 5% bleach solution for 60 seconds and rinsed in sterile water before plating onto 3P Agar. All inoculated plates were incubated at 22 °C, in the dark, and checked periodically over a 14-day period. After initial isolation on to 3P media, the resulting fungal colonies with oomycete mycelial growth characteristics were subcultured onto Potato Dextrose Agar (PDA) or V8 agar [] for purification, and resulting pure cultures were identified and stored under oil for preservation. For identifications, fungal isolates with white mycelia presenting distinct Oomycete growth patterns [] were selected. Samples were prepared for microscopic examination by scraping off a small amount of mycelia and placing it in a drop of lactoglycerol solution (lactic acid, 25 mL; glycerol, 50 mL; distilled water, 25 mL) on a microscope slide []. The samples were then observed for presence of coenocytic hyphae, a morphological characteristic of Phytophthora and Halophytophthora []. Once coenocytic isolates were identified, isolates were flooded with seawater to induce sporangia and zoospore production for identification of Halophytophthora.
2.5. Insecticidal Bioassay
Two different bioinsecticidal assays were used to assess the antagonistic potential of the oomycetes isolated from Hervey Bay biting midge habitats against the biting midge Culicoides subimmaculatus. Other oomycete fungi obtained from DPI, Orange, NSW, Australia were also included in the study to determine whether they would possess any insecticidal properties should local isolates fail to prove to be antagonistic (Table 4).
Table 4.
Results of larval colonization bioassay.
A larval colonisation bioassay adapted from Sweeney [] and an insecticidal metabolite bioassay adapted from Sur et al. [] were used to test the presence of antagonistic activity by the fungal cultures.
A Dialysis Membrane Overlay Technique [] was also used to detect any diffusible antifungal compounds that might be produced by the isolates.
2.6. Statistical Analysis
A chi-square test for independence, performed on SPSS version 14.0 for windows, was used to determine any association between the presence/absence of oomycete fungi and biting midge larvae.
3. Results
3.1. Detection of Larvae
Figure 1 displays a scatter plot of larval abundance compared to the resulting mangrove densities measured. Larvae were found in moderate to high numbers over a large range of mangrove densities. A Kruskal-Wallis test found no significant association, between the distance within the ripple/mud plain and the abundance of larvae, present (χ2 = 2.808, p ≥ 0.05).
Figure 1.
The abundance of larvae relative to mangrove density (m).
Furthermore, the larvae were found in large numbers within the 0–20 m zones over the sandy and ripple plains. A Kruskal-Wallis test showed that there was a significant association between the distance within the intertidal zones sampled and the abundance of larvae present (χ2 = 53.894, p ≤ 0.001). A chi square test for independence showed there was a significant association between larvae presence/absence with distance zones over the sandy ripple plain (χ2 = 71.752, p ≤ 0.001) (Figure 2).
Figure 2.
Sample distances within intertidal zones along the mud or ripple plain where biting midge larvae populations were located.
Figure 3 shows a scatter plot of sediment sorting compared to the number of larvae found. A Kruskal-Wallis test showed no significant difference between the abundance of larvae and the sorting of sediments (χ2 = 0.482, p ≥ 0.05).
Figure 3.
The sediment standard deviation, expressed as Phi, of samples from Eli Creek and Urangan in comparison to the abundance of larvae found within each sample.
3.2. Fungal Isolations and Identifications
Twenty-six marine Halophytophthora isolates were isolated from Hervey Bay; all resulting from leaf samples of varying decomposition, collected throughout individual transects (Table 2, Figures 4a, b, and c). Halophytophthora isolates were detected mostly in environments with median salinity of 33.16 ppt, temperature of 22.38 °C, and a pH of 7.78 (Table 3).
Figure 4.
(a) Growth patterns of Halophytophthora isolates; (b) Sporangia produced by some of the Halophytophthora isolates; (c) Zoospores of a Halophytophthora isolate.
Halophytophthora isolates were obtained from 50% of the sites where larvae were detected and from 31.3% of sites where larvae were not detected. There was no significant association between the existence of Halophytophthora and the existence of biting midge larvae (Table 5). A chi square test for independence showed no significant association between Halophytophthora and larval existence (χ2 = 0.482, p = ≥ 0.05).
Table 5.
The abundance of larvae found in relation to Halophytophthora existence *.
3.3. Bioassays
In both insecticidal bioassays, larvae matured through to pupae with a small number maturing into adults, indicating absence of true antagonistic activities for all isolates listed in Table 2. All of the isolates tested were associated with both dead and alive pupae; however, the association appeared to be through surface colonization and/or attachment, but not invasion causing death of the host. Isolates tested resulting in observed mycelial growth and attachment to pupae are listed in Table 4 including the isolate USC-021-C4 which resulted in mycelial growth around thoracic segments of two pupae cadavers. Furthermore, no insecticidal activity was present when a diffused fungal metabolite test was performed, with all larvae remaining alive and active throughout the 14-day insecticidal bioassay test period. A large number of larvae matured into pupae, with some then maturing into adult midge by day 14. Both test and control larvae survived remaining alive and active throughout the test period.
4. Discussion and Conclusions
Species of oomycete fungi in particular Halophytophthora were targeted for isolations in this study as they were reported to occur within the marine intertidal environment [] and belong to the Family Pythiaceae (Class Oomycetes), from which, Lagenidium giganteum, biting midge larvae infecting fungus was previously described as a biological control agent [].
Halophytophthora are the first colonizers of mangrove leaves [] essential within the mangrove ecosystem [] and are significant decomposers of leaf litter [,]. If an entomopathogenic species of Halophytophthora associated with the presence of leaf litter and/or specific mangrove species were identified, such a finding could have significance in the search for biological control agents in these environments.
However, no naturally occurring antagonists were detected in this study at the locations of populations of biting midge larvae which may also explain the high numbers of biting midge within the region [,]. There was also no association between the Halophytophthora species isolated and the larval occurrence at the sites sampled. Nakagiri [] suggests that species of Halophytophthora occur when and where environmental conditions suit them. Mangrove ecosystems vary greatly in water salinity [], and pH concentration [,]. They also experience temperature changes, which can vary between 10–20 °C within the 24-hour tidal cycle []. The detection of fungi at temperatures around 20 °C but not above might suggest unsuitable environmental conditions supporting fungal growth in the zone such as higher temperatures at this sub-tropical region.
Further investigation into the relationship between sediments and larval populations over a broader range of habitats, including the influence of mangroves on sediment accumulation within the intertidal environments, might provide further information and contribute to the identification of processes resulting in the accumulation of sediments preferred by biting midge larval populations, or lead to the identification of a method to deter larval populations through sediment manipulation.
In order to be able to design effective biocontrol measures, a thorough understanding is required of the natural habitat and ecology of the antagonistic species so that their suitability as a biocontrol agent can be determined. Naturally occurring fungal species, other than Oomycetes, occurring within intertidal zones could also be investigated to determine whether previously undetected bioinsecticidal fungi may be present within these locations. Alternatively, previously identified antagonistic species such as the Northern New South Wales isolate Lagenidium giganteum (producing mortality rates of up to 33% against C. molestus larvae []) or Culicinomyces clavosporous (shown to be highly pathogenic to the larvae of C. nubeculous []) might also be considered for bio-reinforcement/bioaugmentation strategies for elimination of the biting midge larvae in the infested areas of the region.
The identification of larval habitats within this study is not complete for the Hervey Bay region however; findings of the study may assist future locating, surveying and/or controlling of larval habitats and their natural predators within this area in order to design effective biological control measures to replace currently used environmentally unfriendly chemicals.
Acknowledgments
Authors gratefully acknowledge Ron Neller (USC) for his invaluable support and expertise in the process of sampling at Hervey Bay. Roger Shivas (DPI-Indooroopilly) and Martin Shivas (DPI-Indooroopilly) for providing invaluable support and expertise on fungal and midge aspects of the study respectively. Authors also thank Clive Easton from Tweed Heads Shire Council, Queensland, for his expert advice on sampling, enumeration and identification of the midge larvae. The authors would also like to thank Hervey Bay Council for their unlimited support and assistance with access to sampling sites, knowledge of the area, and unrestricted use of laboratory space and equipment, without whose assistance project samples would have been unobtainable.
References
- Unkles, SE; Marriott, C; Kinghorn, JR; Panter, C; Blackwell, A. Efficacy of the Entomopathogenic Fungus, Culicinomyces clavisporus against larvae of the Biting Midge, Culicoides nubeculosus (Diptera: Ceratopogonidae). Biocontrol Sci. Techn 2004, 14, 397–401. [Google Scholar]
- Shivas, M; Whelan, P; Webb, C. The characterization of emergence sites of the biting midge Culicoides ornatus (Diptera: Ceratopogonidae) in mangroves near Darwin, NT, Australia. Arbovirus Res. Aust 1997, 7, 275–279. [Google Scholar]
- Shivas, M; Whelan, P; Webb, C. The larval biology of Culicoides ornatus (Ceratopogonidae: Diptera) in mangroves near Darwin, Northern Territory, Australia. Supp. Bull. Mosquito Contr. Assoc. Aust 1998, 10, 23–25. [Google Scholar]
- Reye, EJ. The Problems of Biting Midges (Diptera: Ceratopogonidae) in Queensland. Entomol. Soc. Queensland 1964, 3, 1–6. [Google Scholar]
- Wheland, P. Biting Midges or “Sandflies” in the NT. North. Territ. Dis. Control Bull 2003, 10, 1. [Google Scholar]
- Kettle, DS; Reye, EJ; Edwards, PB. Distribution of Culicoides Molestus (Skuse) (Diptera: Ceratopogonidae) in man-made canals in South-eastern Queensland. Aust. J. Mar. Fresh. Res 1979, 30, 653–660. [Google Scholar]
- Wright, PJ; Easton, CS. Natural incidence of Lagenidium giganteum Couch (Oomycetes: Lagenidiales) infecting the biting midge Culicoides molestus (Skuse) (Diptera: Ceratopogonidae). Aust. J. Entomol 1996, 35, 131–134. [Google Scholar]
- Edwards, PB. Seasonal changes in Larval Populations of Culicoides subimmaculatus Lee and Reye (Diptera: Ceratopogonidae), with observations on the influence of tides on larval Ecology. Aust. J. Mar. Fresh. Res 1989, 40, 69–78. [Google Scholar]
- Mellor, PS; Boorman, J; Baylis, M. Culicoides Biting Midges: Their Role as Arbovirus Vectors. Annu. Rev. Entomol 2000, 45, 307–340. [Google Scholar]
- Drolet, BS; Campbell, CL; Stuart, MA; Wilson, WC. Vector competence of Culicoides sonorensis (Diptera: Ceratopogonidae) for vesicular stomatitits virus. J. Med. Entomol 2005, 42, 409–418. [Google Scholar]
- Breard, E; Hamblin, C; Hammoumi, S; Sailleau, C; Dauphin, G; Zientara, S. The epidemiology and diagnosis of bluetongue with particular reference to Corsica. Vet. Res. Sci 2004, 77, 1–8. [Google Scholar]
- Schmidtmann, ET; Bobian, BJ; Belden, RP. Soil chemistries define aquatic habitats with immature populations of the Culicoides variipennis complex (Diptera: Ceratopogonidae). J. Med. Entomol 2000, 37, 58–61. [Google Scholar]
- Jones, RH; Roughton, RD; Foster, NM; Bando, BM. Culicoides, The Vector of Epizootic Hemorrhagic Disease in White-tailed Deer in Kentucky in 1971. J. Wildlife Dis 1977, 13, 2–8. [Google Scholar]
- Garvin, MC; Greiner, EC. Ecology of Culicoides (Diptera: Ceratopogonidae) in South Central Florida and experimental Culicoides vectors of the avian hematozoan Haemoproteus Danilewskyi Kruse. J. Wildlife Dis 2003, 30, 170–178. [Google Scholar]
- Shivas, MA. Hervey Bay Biting Midge Review 2001—Previous Studies and Research Priorities; Report to Hervey Bay City Council: Queensland, Australia, 2001; p. 41.
- Tweed Heads Shire Council. Mosquitoes & biting midges (sandflies) in the Tweed Shire. Available online: http://www.tweed.nsw.gov.au/YourEnvironment/eh_1_mosquit.htm (accessed on 20 April 2011).
- Perich, MJ; Strickman, D; Wirtz, RA; Stockwell, JL; Burge, R; Hunt, G; Lawyer, PG. Field Evaluation of Four Repellents against Leptoconops americanus (Diptera: Ceratopogonidae) Biting Midges. J. Med. Entomol 1995, 32, 306–309. [Google Scholar]
- Webb, CE; Russell, RC. Living with Mosquitoes in the Lower Hunter & Mid North Coast Region of NSW; Premiers Department: Sydney, Australia 2005. , 2nd ed Available online: http://www.hnehealth.nsw.gov.au/__data/assets/pdf_file/0020/63470/Living_With_Mosquitoes_-_2nd_Edition_-_DECEMBER_2009.pdf (accessed on 20 April 2011).
- Royle, A. A new tool for the control of mosquitoes, biting midges and flies. Wing Beats Fla. Mosq. Control Assoc 2004, 15, 18–19. [Google Scholar]
- Wheland, P. Biting midges or “sandflies” in the NT. North. Territ. Dis. Control Bull 2003, 10, 1–12. [Google Scholar]
- Mishra, SK; Keller, JE; Miller, JR; Heisey, RM; Nair, MG; Putnam, AR. Insecticidal and nematicidal properties of microbial metabolites. J. Ind. Microbiol 1987, 2, 267–276. [Google Scholar]
- Strasser, H; Vey, A; Butt, TM. Are there any risks in using entomopathogenic fungi for pest control, with particular reference to the bioactive metabolites of Metarhizium, Tolypocladium and Beauveria species? Biocontrol Sci. Techn 2000, 10, 717–735. [Google Scholar]
- Lacey, IA; Frutos, R; Kaya, HK; Vail, P. Insect pathogens as biological control agents: Do they have a future? Biol. Control 2001, 21, 230–248. [Google Scholar]
- Scholte, EJ; Knols, BGJ; Takken, W. Autodissemination of the entomopathogenic fungus Metarhizium anisopliae amongst adults of the malaria vector Anopheles gambiae. Malaria J 2004, 3, 45. [Google Scholar]
- Jackson, MA. Optimizing nutritional conditions for the liquid culture production of effective fungal biological control agents. J. Ind. Microbiol. Biot 1997, 19, 180–187. [Google Scholar]
- Sah, PA; Pell, JK. Entomopathogenic fungi as biological control agents. Appl. Microbiol. Biot 2003, 61, 431–423. [Google Scholar]
- Peterson, EE; Semon, MJ; Kerwin, JL; Brower, JM. Regulation of attachment, germination, and apressorium formation by zoospores of Lagenidium giganteum and related Oomycetes by chitin, chitosan, and catecholamines. Protoplasma 1997, 197, 96–110. [Google Scholar]
- Newell, SY; Fell, JW. Competition among mangrove Oomycetes, and between Oomycetes and other microbes. Aquat. Microb. Ecol 1997, 12, 21–28. [Google Scholar]
- Pegg, KG; Foresberg, LI. Phytophthora in Queensland Mangroves. Wetlands 1982, 1, 2–3. [Google Scholar]
- Brey, PT; Remaudiere, G. Recognition and isolation of Lagenidium giganteum Couch. Bull. Soc. Vec. Ecol 1985, 10, 90–97. [Google Scholar]
- Deacon, J. Fungal Biology, 4th ed; Blackwell Publishing: Carlton Vic, Australia, 2006; pp. 16–47. [Google Scholar]
- Goudie, A. Geomophological Techniques; George Allen and Unwin: London, UK, 1981. [Google Scholar]
- Hribar, LJ. A review of methods for recovering biting midge larvae (Diptera: Ceratopogonidae) from substrate samples. J. Agr. Entomol 1990, 7, 71–76. [Google Scholar]
- Drenth, A; Sendall, B. Practical Guide to Detection and Identification of Phytophthora, Version 10; CRC for Tropical Plant Protection: Brisbane Australia, 2001. [Google Scholar]
- Boggs, S. Principles of Sedimentology and Stratigraphy, 2nd ed; Prentice Hall: Upper Saddle River, NJ, USA, 1995; pp. 79–91. [Google Scholar]
- Eckert, JW. A selective antibiotic medium for isolation of Phytophthora and Pythium from plant roots. Phytopathology 1962, 52, 771–777. [Google Scholar]
- Principles and Applications of Soil Microbiology, 2nd ed; Sylvia, DM; Hartel, P; Fuhrmann, J; Zuberer, D (Eds.) Prentice Hall: Upper Saddle River, NJ, USA, 2005; p. 638.
- Gerrettson-Cornell, L; Simpson, J. Three new marine Phytophthora species from New South Wales. Mycotaxon 1984, 19, 453–470. [Google Scholar]
- Frankland, JC; Latter, PM; Poskitt, JM. A Laboratory Guide to Soil Microbiology: Some General Principles and Practice; Medewood Research and Development Paper Number 115; Institute of Terrestrial Ecology, Merlewood Research Station, Grange-over-Sands: Cumbria, UK, 1995. [Google Scholar]
- Sweeney, AW. The insect pathogenic fungus Culicinomyces in mosquitoes and other hosts. Aust. J. Zool 1975, 23, 59–64. [Google Scholar]
- Sur, B; Bihari, V; Sharma, A; Joshi, AK. Studies on physiology, zoospore morphology and entomopathogenic potential of the aquatic Oomycetes: Lagenidium giganteum. Mycopathologia 2001, 154, 51–54. [Google Scholar]
- Gibbs, JN. A study of the epiphytic growth habit of Fomes annosus. Ann. Bot 1967, 31, 755–774. [Google Scholar]
- Leaño, EM; Jones, EBG; Vrijmoed, LLP. Why Halophytophthora species are so well adapted to mangroves. Fungal Divers 2000, 5, 131–151. [Google Scholar]
- Neller, DA; Howie, J. The Public Health Impact of Biting Midge in Hervey Bay; Report Prepared for Hervey Bay City Council: Hervey Bay, Queensland, Australia, 2003. [Google Scholar]
- Neller, R. The Public Health Impact of Biting Midge in Hervey Bay; Report Prepared for Hervey Bay City Council: Hervey Bay, Queensland, Australia, 2003. [Google Scholar]
- Nakagiri, A. Ecology and biodiversity of Halophytophthora species. Fungal Divers 2000, 5, 153–164. [Google Scholar]
- Fungal Ecology, 1st ed; Dix, NJ; Webster, J (Eds.) Chapman and Hall: London, UK, 1995.
- Intertidal Ecology; Raffaelli, D; Hawkins, S (Eds.) Chapman and Hall: London, UK, 1996.
© 2011 by the authors; licensee MDPI, Basel, Switzerland. This article is an open-access article distributed under the terms and conditions of the Creative Commons Attribution license (http://creativecommons.org/licenses/by/3.0/).